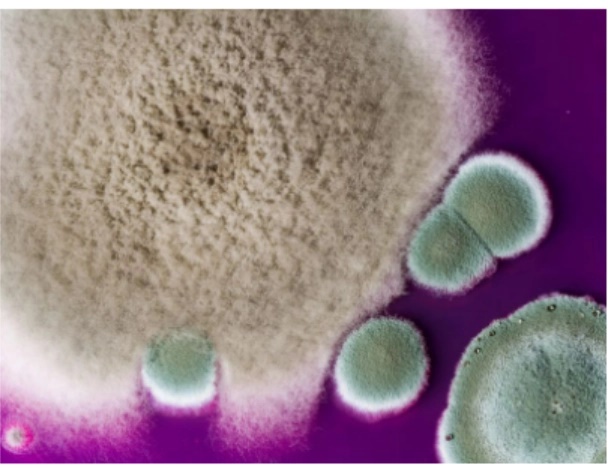
Cảnh báo nấm kháng thuốc có thể lây nhiễm vào phổi người-1

Bệnh Aspergillosis là một nhiễm trùng cơ hội do hít phải các bào tử của nấm sợi Aspergillus (có trong môi trường). Hầu hết mọi người hít thở phải bào tử Aspergillus mỗi ngày mà không bị bệnh. Tuy nhiên, những người có hệ thống miễn dịch suy yếu hoặc mắc bệnh phổi có nguy cơ cao mắc các vấn đề sức khỏe do Aspergillus.
Các loại vấn đề sức khỏe do Aspergillus gây ra bao gồm phản ứng dị ứng, nhiễm trùng phổi và nhiễm trùng ở các cơ quan khác.
Bệnh Aspergillosis ảnh hưởng đến 10 đến 20 triệu người trên toàn thế giới, thường được điều trị bằng thuốc chống nấm, nhưng có bằng chứng về sự kháng thuốc mới xuất hiện và ngày càng gia tăng.
Nấm trong môi trường có thể lây nhiễm trong phổi người kháng thuốc nguy hiểm.
Sự kháng thuốc này là do việc sử dụng rộng rãi thuốc diệt nấm azole trong nông nghiệp, tương tự như thuốc azole được sử dụng để điều trị bệnh nấm aspergillosis, theo các tác giả nghiên cứu.
GS Matthew Fisher, Trường Y tế Công cộng tại Đại học Imperial (Anh), đồng tác giả nghiên cứu, cho biết: "Việc tìm hiểu các điểm nóng về môi trường và cơ sở di truyền của sự phát triển tính kháng thuốc của nấm cần được quan tâm khẩn cấp, bởi vì sự kháng thuốc đang ảnh hưởng đến khả năng ngăn ngừa và điều trị căn bệnh này".
Các nhà nghiên cứu đã phân tích DNA của 218 mẫu Aspergillus fumigatus (A. fumigatus) từ Anh, Wales, Scotland và Ireland trong khoảng thời gian từ 2005 đến 2017. Khoảng 7/10 mẫu là từ những người bị nhiễm bệnh và các mẫu khác là từ môi trường, bao gồm từ đất, phân trộn, củ cây, không khí và các nguồn khác.
Trong số 218 mẫu, gần một nửa kháng với ít nhất một loại thuốc azole đầu tiên. Cụ thể, 48% đề kháng với itraconazole, 29% với voriconazole và 21% với posaconazole.
Hơn 10% mẫu (bao gồm 23 mẫu trong môi trường và 3 mẫu từ bệnh nhân) đã kháng với hai hoặc nhiều loại thuốc azole.
Trong 218 mẫu, các nhà nghiên cứu đã tìm thấy 50 gen mới liên quan đến kháng thuốc và 5 tổ hợp thay đổi DNA mới liên quan đến kháng thuốc, trong đó có một gen kháng nhiều loại thuốc.
GS Fisher cho biết: "Tỷ lệ nhiễm aspergillosis kháng thuốc đã tăng từ mức không đáng kể trước năm 1999 lên đến 3% - 40% các trường hợp hiện nay trên khắp châu Âu. Đồng thời, do có nhiều người được cấy ghép tế bào gốc hoặc nội tạng rắn, đang điều trị bằng thuốc ức chế miễn dịch, mắc các bệnh về phổi hoặc nhiễm trùng đường hô hấp do virus nặng... nên tăng nguy cơ nhiễm Aspergillus fumigatus".
Theo các nhà khoa học, cần phải theo dõi nhiều hơn đối với A. fumigatus trong môi trường và bệnh nhân để giúp hiểu được nguy cơ mà nó gây ra để ứng phó thích hợp.
Theo Sức Khỏe Đời Sống
